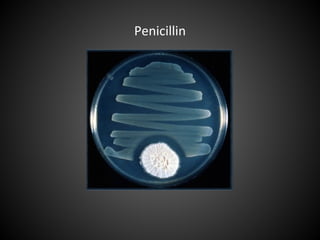
Penicillin

Peter Llewellyn introduces himself as the director of several medical communications companies and provides an overview of his background. He discusses the pharmaceutical industry and some key points about drug development costs and timelines. Medical communications is introduced as providing consultancy services to help raise awareness of medicines through education and promotion. Llewellyn suggests ways his resources could help provide an edge for those interested in entering the field of medical communications.